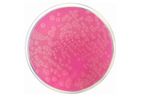
Condalab - Model 1391 - Acetamide Agar Dehydrated Culture Media

Show results for
Refine by
Industries served
- Medical / Health Care
- Chemical & Pharmaceuticals
- Manufacturing, Other
- Packaging
- Monitoring and Testing
- Water and Wastewater
- Agriculture
- Oil, Gas & Refineries
- Paint
- Plastics & Resins
- Energy
- Waste and Recycling
- Food and Beverage
- Pulp & Paper
- Maritime/Shipbuild/Water Transport
- Textile
- Aerospace & Air Transport
- Commercial
- Logistics
- Leather & Tanning
- Metal
- Environmental
- Health and Safety
- University / Academia / Research
- Construction & Construction Materials
Industrial Cosmetic Suppliers Serving Myanmar
82 companies found

Premium
based inRignano S.Arno (Firenze), ITALY
C&G Evaporator is the leading company in the design and production of vacuum evaporators. Water is life, and far too precious a resource to be wasted. We know this well at C&G Evaporator, which is why we create solutions capable of significantly ...

Premium
based inEaston, PENNSYLVANIA (USA)
Vobis, LLC. About 20 years ago, after working for over a dozen years for several dedicated manufacturers of evaporation, crystallization, and drying technologies. Vobis designs and manufactures systems that meet your unique requirements and budget ...

based inBanyoles, SPAIN
Founded in Banyoles, Spain, INOXPA is a renowned and long-standing business group specialised in the manufacture and sale of stainless steel fluid handling components and equipment, management of processes and services in the food-processing, ...

based inBarmer, INDIA
Established in 1980, we, 'Mahesh Agro Food Industries' are the manufacturer, supplier, and exporter of hydrocolloids, animal feed ingredients, grains, spices, and herbs in Barmer, Rajasthan, India. We are the government of India recognized star ...

based inMumbai, INDIA
The story of the company is about harnessing the fruits of science for goals that go beyond business. The story of the company is about harnessing the fruits of science for goals that go beyond business. We operate through two verticals - Basic ...

based inSongjiang District, CHINA
Established in 2006, Shanghai Huihe Industrial Co., Ltd is a standardized modern enterprise specialized in R&D, design, manufacturing, sales, and technical support of various kinds of packaging machinery. We have factories in Shanghai, Guangdong and ...

based inKarlsruhe, GERMANY
Romaco Group specializes in the development and production of processing and packaging machinery specifically aimed at sectors like pharmaceuticals, nutraceuticals, food, cosmetic, and chemical industries. They offer a myriad of solutions including ...
based inGandhidham, INDIA
We offers aluminum tubes and laminated tubes for pharmaceutical, cosmetic and food packaging industries from 60 yr old Company, Montebello Packaging, Canada. These tubes are DMF registered. Montebello Packaging is specialized in manufacturing of ...

based inWysogotowo, POLAND
Kegel Machines specializes in providing a wide array of production and packaging machines tailored for the food and cosmetics industries, among others. The company is known for its robust offerings in automated and semi-automated machinery, ...

based inSpring, TEXAS (USA)
United Pharmatek specializes in supplying and custom manufacturing high-quality, affordable processing, packaging, and laboratory equipment. With over two decades of experience, we serve the pharmaceutical, nutraceutical, cosmetic, food, and ...

based inLumezzane (BS), ITALY
4G Ghidini SRL, founded in 1978, is a leading manufacturer of stainless steel ball valves and fittings designed for applications in sectors such as chemical, pharmaceutical, food and beverage, and water treatment industries. The company emphasizes ...

based inBudapest, HUNGARY
CycloLab is a worldwide recognized and all-around cyclodextrin research and development company, having the longest tradition and broadest circle of customers. Since 1972, a staff of internationally acknowledged experts have been working in the ...
Cyclodextrins have been used in food products and nutraceutics for decades as stabilizers for flavors and colorants, solubilizers of vitamins and lipophilic components, taste and odor maskers or to improve hygroscopicity, powder properties, even as ...

based inMönchengladbach, GERMANY
Surely you’ve heard this many times before. With us, however, it's filled with life and is the core of our company policy. With us, you simply get more than the standard. Especially in the pharmaceutical industry, for which we as specialists produce ...

based inCrailsheim, GERMANY
groninger, the name stands for innovation, quality and service in the design of customized machines for the Pharmaceutical, Cosmetics and Consumer Healthcare industry. We have proven it to our customers for 39 years. Customer focus for groninger is ...
Our team of qualified, experienced technicians are just a call away – providing an extensive after-sales network with many clearly defined services. Operating in the pharmaceutical, cosmetic and consumer healthcare ...

based inTorrejón de Ardoz, SPAIN
Founded in 1960, Condalab is Spain's first dehydrated culture media for microbiology and molecular biology manufacturer, as well as one of the world's leading ones. Condalab is also recognized for offering key ingredients such as agars, peptones and ...
Acetamide Agar For the differentiation of non fermentative Gram negative bacteria, in particular Pseudomonas ...

based inSpianate Altopascio, ITALY
With over 40 years in operation, CO.RA. srl specializes in providing systems for intercepting, dosing, regulating, and transporting solid products like powders, tablets, capsules, and granules across chemical, pharmaceutical, food, and cosmetics ...

based inNemours, FRANCE
Design, equipment, instrumentation, safety, hygiene, protection, and material for all phases of the analytical process, LABELIANS supports laboratories throughout France and around the world, in medical biology, industry, research and academic ...

based inBerlin, GERMANY
SCIENION is a global market leader in ultra-low volume precision dispensing and microarray as well as biosensor technologies. Our customers in the entire life science sector benefit from an integrated product portfolio and services advancing ...

based inClydach, UNITED KINGDOM
Our cutting-edge technology is transforming the market with the incredible potential of microalgae, offering sustainable and eco-friendly solutions for a brighter future. At API, we have mastered the art of separating algae and harnessing its full ...
As a highly sought-after ingredient, Astaxanthin is widely utilized as a dietary supplement, a functional component in food and beverages, and an additive in animal feed and aquaculture to enhance coloration and overall well-being. Unleash its ...

based inMonmouth Junction, NEW JERSEY (USA)
MedChemExpress (MCE) offers a wide range of high-quality research chemicals and biochemicals (novel life-science reagents, reference compounds and natural compounds) for scientific use. We have professionally experienced and friendly staff to meet ...
Collagen, Type I, from bovine achilles tendon are extracellular matrix proteins and show many applications in food, cosmetic, pharmaceutical and biomedical industries. Collagens play an important role in the ...